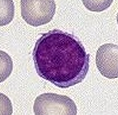

LEUCOPOYESIS. Formación de los agranulocitos.
Los agranulocitos son los leucocitos que carecen de gránulos, entre ellos se encuentran los monocitos y los linfocitos.
MONOCITOS
Célula troncal a monoblasto
Figura 21. Leucocitos granulares y agranulares
Fuente: (producción y vida de los leucocitos, s.f)
La teoría actual sostiene que los monocitos y los macrófagos se dividen en: monoblastos, promonocitos, monocitos sanguíneos y macrófagos libres y fijos. Por acción de la IL-3, GM-CSF y M-CSF, el monoblasto se genera a partir de la CFU-GEMM y se encuentra en mayor medida en la médula ósea, aunque algunos lugares secundarios posibles son el bazo y otros sitios reticuloendoteliales (Rodak, 2007).
Secuencia de maduración:
Monoblasto
Figura 22. Monoblasto. Muestra: Médula ósea (MO)
Tinción: Wright. Aumento: 100x
Fuente: (Amaya, 2014; febrero)
Los monoblastos se encuentran en bajas cantidades en la médula ósea, y su única función se produce durante la mitosis (Rodak, 2007).
Núcleo: Localizado de manera excéntrica que contiene uno o dos nucléolos visibles (Rodak, 2007).
Citoplasma: No es granular y cuando se tiñe se presenta débilmente positivo para la peroxidasa (Rodak, 2007).
Diferenciación: se diferencia a promonocito (Rodak, 2007).
Promonocito
Figura 23.Promonocito. Muestra: MO
Tinción: Wright. Aumento: 100x
Fuente: (Amaya, 2014; febrero)
Los promonocitos son similares en tamaño a los blastos, aunque contienen cierta granulación. Pueden ser móviles y participar en la fagocitosis (Rodak, 2007).
Núcleo: doblado, torcidos o con muescas (Rodak, 2007).
Citoplasma: Irregular (Rodak, 2007).
Diferenciación: Se diferencia a monocito.
Monocito
Figura 24. Monocito Muestra: Sangre periférica (sp)
Tinción: Wright. Aumento: 100x
Fuente: (Amaya, 2014; febrero)
Núcleo: Mellado o curvo con cromatina reticular con pequeños grumos, y en los casos típicos se describe como la célula más grande en sangre periférica.
Citoplasma: Abundante, lleno de gránulos diminutos dispuestos en remolinos, que producen una apariencia nublada o turbia. La membrana citoplasmática puede ser bastante irregular.
Función: Actividad fagocitaria.
Diferenciación: Una vez en los órganos, se transforma en macrófagos, lo que se refleja en el aumento en la capacidad fagocítica, de las sínstesis de proteínas, el número de lisosomas y la cantidad de aparato de Golgi, microtúbulos y microfilamentos (Conceptos básicos del sistema inmunitario, s.f).
LINFOCITOS
La célula troncal para la célula linfoide (CFU-L) madura en distintos sitios. El timo y la médula ósea producen linfoctios, estimulan la diferenciación y son independientes de la estimulación antigénica. Las células que se desarrollan bajo la influencia del timo se denominan linfocito T y tienen un conjunto de receptos y respuestas específicos y únicos. Los linfocitos B provienen de la médula ósea y poseen un conjunto de funciones y capacidades diferentes (Rodak, 2007).
Secuencia de maduración
Linfoblasto
Figura 25. Linfoblasto Muestra: MO
Tinción: Wright. Aumento: 100x
Fuente: (Amaya, 2014; febrero)
El linfoblasto es una célula de tamaño pequeño a mediano (10 -18 µm) (Rodak, 2007).
Núcleo: Redondo a ovalado que contiene cromatina laxa y uno o más nucléolos activos (Rodak, 2007).
Citoplasma: es escaso y presenta basofilia en grado proporcional a la cantidad de ARN presente (Rodak, 2007).
Diferenciación: Se diferencia a linfocito (Rodak, 2007).
Prolinfocito
Figura 26. Prolinfocito Muestra: MO
Tinción: Wright. Aumento: 100x
Fuente: (Amaya, 2014; febrero)
Núcleo: cromatina levemente más condensada que en el linfoblasto, una reducción en la prominencia nucleolar, cambio en la membrana nuclear (Rodak, 2007).
Linfocito
Figura 27. Linfocito Muestra: SP
Tinción: Wright. Aumento: 100x
Fuente: (Amaya, 2014; febrero)
Cuadro 4. Variaciones morfológicas de los linfocitos
Fuente: (Rodak, 2007; p. 137)
La morfología de los linfocitos varía sobre todo en el tamaño. Esta diferencia puede deberse a la actividad de la célula o a la localizacion en el extendido en la que se encuentra. La forma más común es el linfocito pequeño, de alrededor de 9 µm de diámetro (Rodak, 2007).
Núcleo: Redondo a oval y su patrón de cromatina es en bloque (Rodak, 2007).
Citoplasma: escaso y unos pocos gránulos azurófilos (Rodak, 2007).
División: No se divide o se encuentra en estado de reposo (Rodak, 2007).
Referencias bibliográficas:
Amaya, B. (2014, febrero). Diferenciación de células monocíticas y linfocíticas. [Web blogspot]. Recuperado de: http://www.proasecal.com/front/index.php?option=com_content&view=article&id=492:muestra-137&catid=16:hematologia-morfologia
Conceptos básicos del sistema inmunitario. (s.f). EN Principales enfermedades de nuestro tiempo. Recuperado de: http://www.juntadeandalucia.es/averroes/~29701428/salud/inmu.htm
Producción y vida de los leucocitos. (s.f). EN Sabelotodo.org. Recuperado de: http://www.sabelotodo.org/fisiologia/leucocitos.html
Rodak, B. (2007). Hematología: fundamentos y aplicaciones clínicas. (2da. E). Recuperado de: http://books.google.com.gt